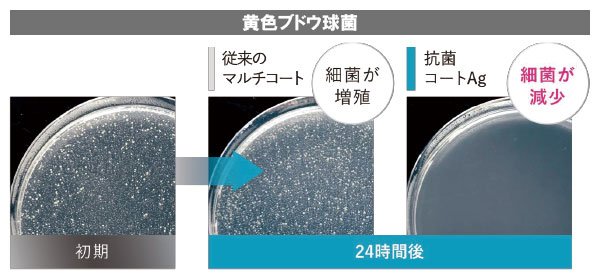

れんず屋総合TOPページ > 東海光学 抗菌AG(エージー)

2021年4月1日発売(MSCAg)
2021年6月1日追加(PGCAg)
2021年7月1日追加(BCCAg)
2021年6月1日追加(PGCAg)
2021年7月1日追加(BCCAg)

■抗菌コートAgとは?
○「銀(Ag)」の力に注目
最近は「銀イオン」「清潔」といったキーワードの商品である、消臭スプレー、抗菌マットなどが、生活に身近なところで多く活用されています。
新しい日常において、毎日身に着けるメガネレンズも清潔に保ち、衛生的に掛けて欲しいと言う思いから、銀の抗菌作用に注目しました。
新しい日常において、毎日身に着けるメガネレンズも清潔に保ち、衛生的に掛けて欲しいと言う思いから、銀の抗菌作用に注目しました。


○ 新開発した独自の技術「抗菌コートAg」

○「銀(Ag)」と「反射防止膜」を組み合わせた抗菌コートAg



■ 抗菌コートAgの仕組み
銀(Ag)がレンズ表面の細菌の増殖を抑制

○ 銀による抗菌のメカニズム
銀(Ag)が微生物(細菌)の代謝系の酵素の働きを阻害することで抗菌作用を発揮


■ 優れた抗菌効果

※殺菌、除菌、抗菌の違いは?



■ 対応レンズ
- 屈折率1.76 / 1.70 / 1.67 / 1.60 の素材商品に対応(一部商品を除く)
- 屈折率1.76 / 1.70 / 1.67 / 1.60 のルティーナ素材商品に対応(一部商品を除く)
- ※調光、偏光、ナイトドライブ、EYE楽GOLF50、バイフォーカルは対応できません。
○ 販売価格
対応レンズのMSC/BCC/PGC → MSCAg/BCCAg/PGCAg
MSC/BCC/PGC 価格+¥3,300
MSC/BCC/PGC 価格+¥3,300